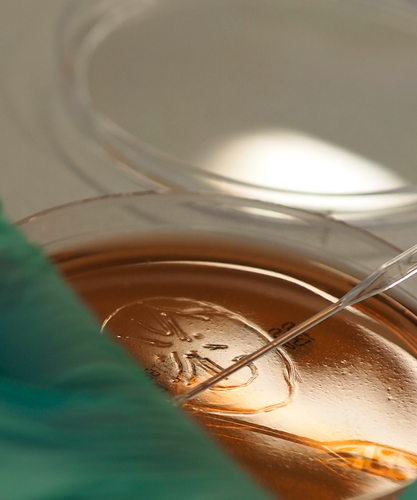
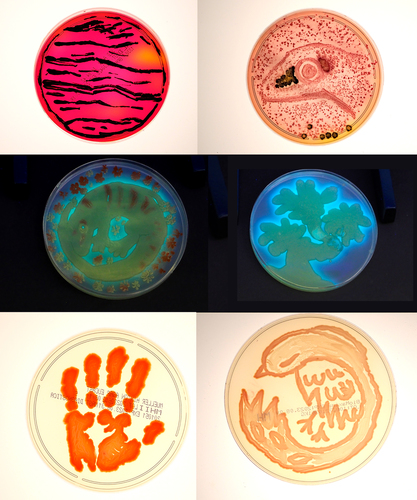

Warsztaty popularnonaukowe w KiZ Mikrobiologii Farmaceutycznej
20.06.2023
Uczniowie Państwowego Liceum Plastycznego w Gdyni im. Magdaleny Abakanowicz wzięli udział w warsztatach pt. Bio-Art zorganizowanych w dniach 13-14 czerwca 2023 r. w Katedrze i Zakładzie Mikrobiologii Farmaceutycznej GUMed. Tematem przewodnim spotkania była sztuka wykorzystania żywych organizmów – w tym przypadku bakterii – jako tworzywa artystycznego. Uczestnicy warsztatów mogli przekonać się, jaki jest efekt spotkania sztuki z biologią. Mieli oni do dyspozycji kilka gatunków bakterii oraz kilka rodzajów agarowych pożywek, na których mikroorganizmy rosną, tworząc kolorowe kolonie. Młodzi twórcy wykorzystali drobnoustroje jako „pigment” a pożywki na szalkach Petriego jako „płótno”. W rezultacie powstały niezwykłe, unikalne dzieła.
Wstępem do zajęć był wykład dr. hab. Krzysztofa Walerona, kierownika Katedry i Zakładu Mikrobiologii Farmaceutycznej poświęcony historii budynku Wydziału Farmaceutycznego GUMed przy al. gen. Józefa Hallera 107 w Gdańsku, pełniącego pierwotnie funkcję liceum dla dziewcząt (Szkoła im. Heleny Lange). Druga część prelekcji dotyczyła metodyki pracy z bakteriami, zasad bezpieczeństwa pracy w laboratorium mikrobiologicznym oraz metodyce dokumentacji prac mikrobiologicznego Bio-Art.

Zajęcia praktyczne prowadzili specjalistki z Katedry i Zakładu Farmaceutycznej: dr Jolatna Ficińska-Mazurczyk i dr Maria Bartoszewicz, które pomagały uczestnikom doskonalić technikę posiewu na agarze, a także dobrać gatunek bakterii i pożywkę do ich wzrostu, by uzyskać oczekiwany efekt artystyczny. Agata Zygadło pokazywała, w jaki sposób sfotografować płytkę, aby wydobyć wszystkie walory rysunku. Płytki fotografowane były w odpowiednim oświetleniu, na białym lub ciemnym tle oraz w świetle UV o różnej długości fali.

Oprócz zajęć w laboratorium uczestnicy warsztatów zwiedzili:
- Katedrę i Zakład Toksykologii, gdzie wysłuchali wykładu o technikach wykrywania narkotyków, który poprowadzili doktoranci Małgorzata Wacławik i Wojciech Rodzaj,
- Katedrę i Zakład Farmacji Stosowanej, gdzie po wprowadzeniu przez kierownik jednostki prof. Małgorzatę Sznitowską, Katarzyna Krzemińska przedstawiła uczestnikom podstawowe informacje na temat produkcji leków i zaprezentowała wykorzystywaną do tego aparaturę,
- Ogród Roślin Leczniczych, po którym oprowadziła ich Izabela Kobierska z Katedry i Zakładu Farmakognozji.
fot. Agata Zygadło/GUMed